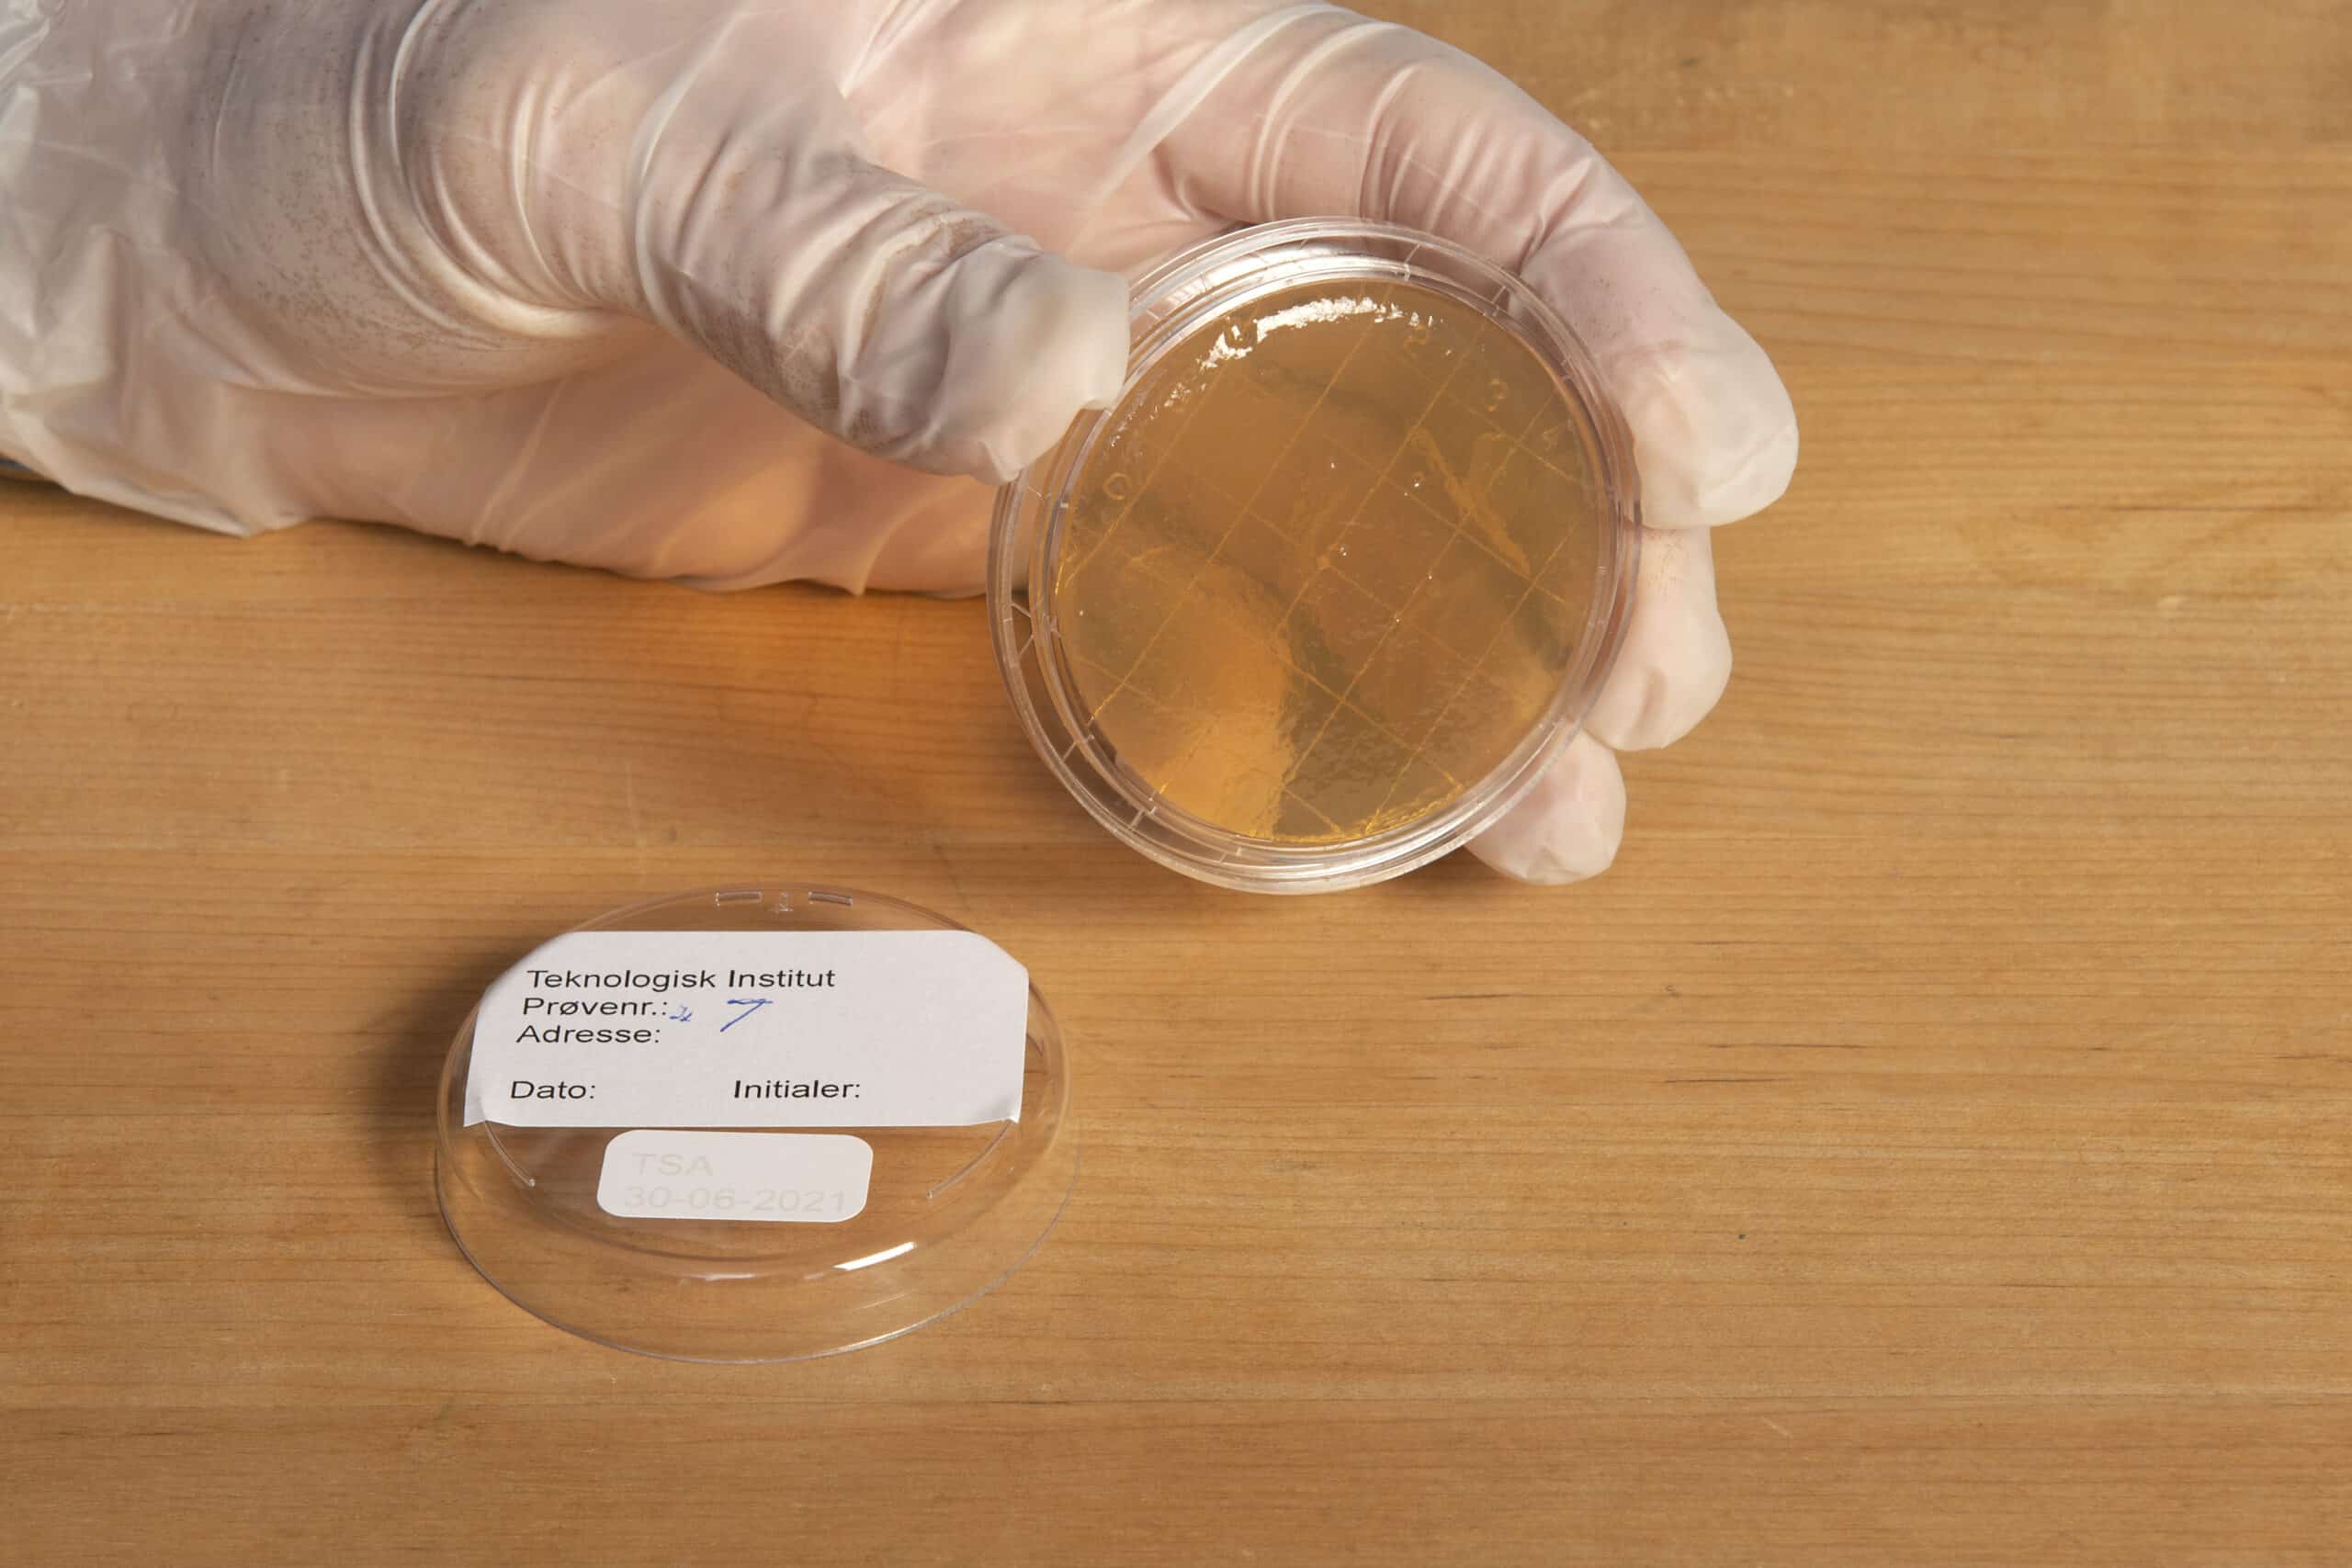
mikrobitestin tekeminen

Rajua kasvua kuppa- ja tippuritartuntojen määrissä
Vuonna 2022 Suomessa todettiin hälyttävän voimakasta kasvua kuppa- ja tippuritartuntojen määrissä. Tartuntarekisterin mukaan nämä seksitaudit kaksinkertaistuivat edellisvuoteen verrattuna. Erityisesti tippurin osalta tilanne on huolestuttava, sillä